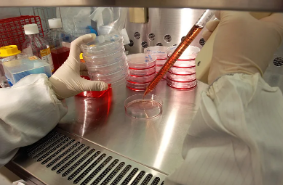
image.png

內膜干細胞灌注的作用是什么,功效如何
2024-11-18 15:56:01 來源: 小編 咨詢醫(yī)生
本文將深入探討內膜干細胞灌注的作用機制及其在臨床治療中的應用,幫助大家更好地了解這一領域的前沿動態(tài)。
內膜干細胞灌注的作用:
1.促進組織修復與再生
內膜干細胞具有多向分化潛能,可以分化為內皮細胞、平滑肌細胞、心肌細胞等。當組織受到損傷時,內膜干細胞可以迅速分化為受損組織的細胞類型,促進損傷部位的組織修復與再生。
2.改善血液供應
內膜干細胞可以分化為血管內皮細胞,促進血管新生,改善受損組織的血液供應。這對于治療心血管疾病、肢體缺血等疾病具有重要意義。
3.調節(jié)免疫反應
內膜干細胞具有一定的免疫調節(jié)作用,可以抑制T細胞增殖,降低炎癥反應。在自身免疫性疾病、炎癥性腸病等疾病的治療中,內膜干細胞灌注具有潛在的應用價值。
4.提高藥物治療效果
內膜干細胞可以作為一種藥物載體,將藥物定向輸送到受損組織,提高藥物治療效果。此外,內膜干細胞本身也具有抗炎、抗氧化等作用,有助于減輕疾病癥狀。
內膜干細胞灌注的功效:
1.治療心血管疾病
內膜干細胞灌注可以促進心血管內皮細胞再生,修復損傷的心肌組織,改善心臟功能。對于心肌梗死、心力衰竭等心血管疾病患者,內膜干細胞灌注具有顯著的治療效果。
2.治療神經系統(tǒng)疾病
內膜干細胞可以分化為神經元、膠質細胞等,用于治療神經系統(tǒng)疾病,如帕金森病、阿爾茨海默病等。通過內膜干細胞灌注,可以改善患者癥狀,提高生活質量。
3.治療骨骼系統(tǒng)疾病
內膜干細胞可以分化為骨細胞、軟骨細胞等,用于治療骨折、骨關節(jié)炎等骨骼系統(tǒng)疾病。內膜干細胞灌注有助于加速骨折愈合,減輕關節(jié)炎癥狀。
4.治療皮膚疾病
內膜干細胞可以分化為皮膚細胞,用于治療燒傷、皮膚潰瘍等疾病。內膜干細胞灌注可以促進皮膚修復,縮短愈合時間。
總之,內膜干細胞灌注在多種疾病治療中具有重要作用。隨著科學技術的發(fā)展,對內膜干細胞的研究將更加深入,其在臨床應用的前景也將更加廣闊。然而,內膜干細胞灌注治療仍需克服一系列技術難題,如干細胞來源、分化調控、安全性等,以確保其在臨床應用中的安全性和有效性。
-
下一頁: 如何提高干細胞轉化率,需要什么流程
- 2024-10-25我國干細胞有資質公司有哪些
- 2024-08-06毛囊干細胞再生技術,毛囊干細胞再生技術是真的嗎
- 2024-08-29干細胞的活性與效果,臨床應用中的真實表現(xiàn)
- 2024-10-14造血干細胞為何屬于干細胞?其獨特性體現(xiàn)在哪里?
- 2024-10-15干細胞的作用和功效,干細胞的應用范圍
- 2024-11-13獻干細胞過程是怎么樣的,流程復雜嗎
- 2024-10-10神經干細胞移植效果怎樣,它與傳統(tǒng)治療有何不同
- 2024-10-11干細胞培植皮膚技術成熟嗎?效果可以持續(xù)多久?
- 2024-09-13臍帶血造血干細胞存儲有意義嗎,能治療哪些疾病
- 2024-08-30干細胞移植是骨髓移植嗎,附具體操作流程
- 2024-09-06神經干細胞移植能治什么病,成功率高嗎
- 2024-10-01常德干細胞捐贈靠譜嗎,如何選擇正規(guī)捐贈機構
- 2024-09-13蘋果干細胞原液的作用與功效和注意事項
- 2024-10-11造血干細胞捐獻的意義是什么?如何提高大眾對其認識?
- 2024-08-29乳牙干細胞儲存多少錢作用大嗎
- 2024-07-29造血干細胞捐獻流程,造血干細胞捐獻年齡范圍
- 2024-09-11哪里可以注射干細胞,干細胞注射機構排名
- 2024-09-27干細胞具體有哪些作用?在醫(yī)療領域應用廣泛嗎?
